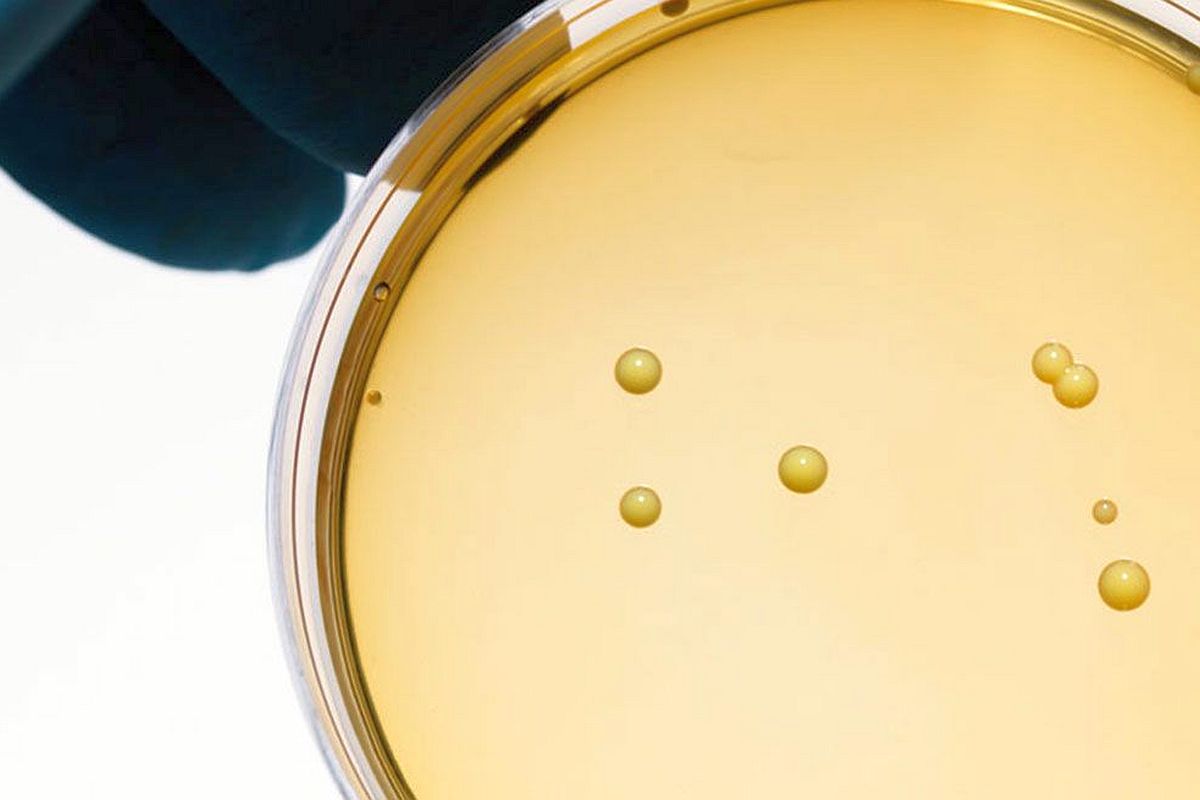

BellHawk Online
Powerful, pay as you go, easy to use barcode tracking
Pharmaceuticals

Materials · Operations · Tracking · Traceability
The Pharmaceutical Operations Tracking and Traceability System (POTTS) provides a low-cost and easy-to-use Cloud-based solution that enables small to mid-sized organisations to comply with EU/FDA materials tracking and traceability requirements. Also suitable for biotechnology and life sciences.
Pharmaceutical Operations Tracking and Traceability System (POTTS) is intended for organizations that make pharmaceuticals and need to comply with FDA materials traceability requirements as well as DSCSA serialization requirements. POTTS consists of the Real-Time Operations Tracking System (RT-OPS) plus the Warehouse Management (WMS), materials traceability (TRACE) and the Quality Control (QC) modules. It is especially suited to smaller pharmaceutical manufacturers who are seeking an affordable CFR 21 Part 11 compliant solution.
The Pharmaceutical Operations Tracking and Traceability System (POTTS) provides a low-cost and easy-to-use Cloud-based solution that enables small to mid-sized organisations to comply with EU/FDA materials tracking and traceability requirements.
POTTS is suitable for use by small to mid-sized manufacturers of pharmaceutical products, such as CMOs, makers of OTC pharmaceutical products, repackagers, as well as biotechnology and specialty manufacturers of pharmaceutical products in limited quantities. With the addition of WMS, the BellHawk Online Warehouse Management option, POTTS is also suitable for use by distributors that purchase pharmaceuticals in bulk but distribute these to their customers in small volume.
POTTS captures end-to-end materials tracking and traceability data to enable sending pedigree data to customers and data repositories by means of EDI or EPCIS data transmission.
POTTS replaces the use of paper forms and manual keyboard data entry with the use of barcode technology to reduce the amount of labor required for record keeping as well as preventing mistakes.
With the addition of the BellHawk Label Printing System (BLPS), within a facility, POTTS can print out DSCSA (Drug Supply Chain Safety Act) compliant 2D barcodes for application to bottles and cartons of pharmaceutical products using automated applicators or manual application.
POTTS can also print GS1 compliant barcodes on demand for application to boxes in which products are packed for shipment and shrink-wrapped pallets on which the boxes are stacked.
POTTS was developed to be compliant with CFR 21 Part 11 requirements and a data package can be made available to facilitate certification of the system to be in compliance with FDA good manufacturing practices.
POTTS is specifically designed for use by small to mid-sized organization and costs much less to implement than using materials tracking and traceability systems designed for use by large pharmaceutical organizations.
What the BellHawk Online POTTS System Tracks
The BellHawk Pharmaceutical Operations Tracking System (POTTS) is used by small and mid-sized manufacturers and distributors of FDA regulated pharmaceutical products.
BellHawk POTTS is specifically designed for use by small to mid-sized organization and costs much less to implement than using materials tracking and traceability systems designed for use by large pharmaceutical organizations.
POTTS:
Tracks materials by lot and serial number and location. Tracks what materials were used in the manufacture of which intermediate or finished products Builds a traceability database to enable rapid tracking back to the source of defects or contamination and a rapid limited recall of resultant defective products. Tracks compliance with an organization's quality assurance plan by tracking every step of the manufacturing process, including quality control approvals and the collection of test data. Helps ensure correct labeling by automatically printing product and customer specific labels based on the contents of its database. POTTS manages the assignment of serial numbers to each product container to ensure that each serial number issued is unique. POTTS also tracks details about each product container related to its serial number including all details of its pedigree as well as who and when and how it was shipped and how it was packed.
Through a web portal, POTTS provides clients, and their customers, with the ability to rapidly determine if a product is counterfeit simply by scanning the 2D barcode attached to the product label. It can also show all the products, by serial number, packed into a box or pallet simply by scanning the barcodes on these containers.
POTTS is able to rapidly track back from each serial numbered product to all the ingredients that went into the product as well as who was involved in its manufacture. POTTS can also trace forward from defective ingredients or packaging materials to all the places defective products were shipped.
POTTS collects all the ASN (Advanced Shipment Notice) data for each shipment, including serial numbers of the products and the nested containers in which they were packed. This data can be sent on demand using a third party Cloud-based EDI system or the EPCIS data for the shipment exported to the client's own computer either as a manually transferred file or through the BellHawk Online web services interface.
By special order, POTTS can be integrated with automated labeling and vision inspection systems in high volume production lines, with POTTS generating the serial numbers and tracking product inspection failures as well as tracking packing information.
Related Applications

The Converting Operations Tracking and Traceability System is specifically designed for organizations that convert rolls and sheets of material into products.














